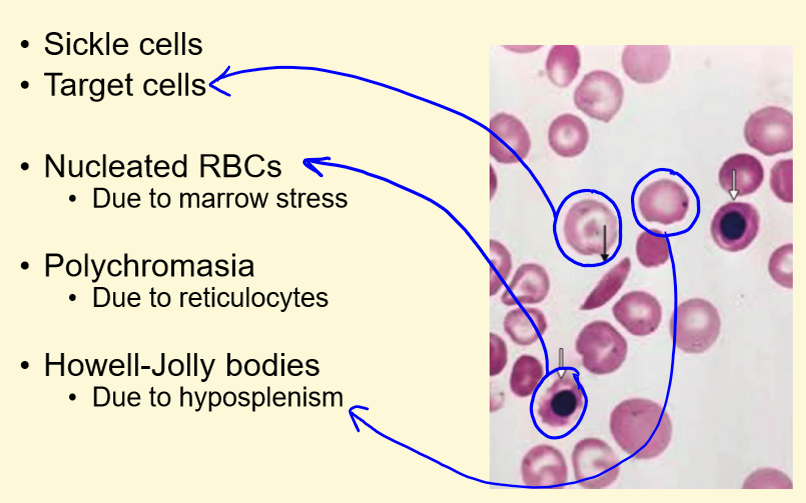

Sickle Cell Anaemia
1/45
There's no tags or description
Looks like no tags are added yet.
Name | Mastery | Learn | Test | Matching | Spaced | Call with Kai |
|---|
No analytics yet
Send a link to your students to track their progress
46 Terms
What is SICKLE CELL DISEASE?
1) Caused by a point mutation in b globin gene
2) Homozygous recessive disease (carriers are heterozygous)
3) Substitution of glutamate to valine at 6th amino acid position causes HbS (substitution of glutamate to lysine causes HbC)
How does the mutation cause sickle cell disease?
1) On deoxygenation, HbS forms parallel aggregates
2) Valine substitution stabilises this conformational change causing sickling (aggregate formation) – this is a qualitative Hb change
3) Red cell shape is deformed into sickle shape
In what GENE is the sickle cell mutation?

Sickle Cell - Morphology

How is sickle cell anaemia INHERITED?

What effect does sickle cell anaemia have on BLOOD VESSELS?
1) Increased mechanical fragility of red cells in sickle cell disease results in shortened lifespan (approx 10 days)
2) Crises are caused by pathological effects of sickled red cells in the blood vessels
3) The rigidity of sickle cells results in increased blood viscosity with occlusion of small blood vessels
4) Adhesion of sickle cells to endothelium blocks vessels
What is the DISTRIBUTION of sickle cell anaemia/
1) Primarily affects Black Afro-Caribbean population
2) Also present in India, Middle East and North Africa
3) Distribution of SCD correlates with regions where malaria is endemic (Plasmodium falciparum carried by female Anopheles mosquito)
4) Small selective advantage of sickle trait against malaria infection
Global Disease Burden of sickle cell anaemia
1) Most common genetic haemoglobinopathy
2) 6 million individuals are affected globally
3) Over 275,000 children are born with SCD annually
4) 80% global SCD burden in Africa
50 UK:
12,500 to 15,000 people living with SCD in UK
240,000 sickle cell trait carriers in the UK
What is the SURVIVAL RATE of sickle cell anaemia?
1) Median survival without good management:
42 years men
46 years women
How is sickle cell anaemia COMPENSATED in the body?
1) Anaemia compensated by 2,3-DPG
2) This moves the oxygen dissociation curve to the right
3) Oxy-haemoglobin releases its oxygen to the tissues at higher levels of tissue oxygen

What are the MAIN CLINICAL FEATURES of sickle cell anaemia?

What are the OTHER COMPLICATIONS of sickle cell anaemia?

What is VASO-OCCLUSIVE CRISIS?
1) Caused by sickling of red cells in the small vessels
2) Can be triggered by cold temperature, infection, lactic acidosis, hypoxia, altitude, flights, viral illness
3) Severe unrelenting pain requiring opiate analgesia (absense of pain)
4) Results in tissue ischaemia
5) Often affects the limbs, back, chest
6) Can occur in organs causing tissue damage
Typical Case Study: Clinical History
1) 27 year old male with known HbSS
2) 2 week history of cough
3) No response to oral clarithromycin (bacterial antibiotic)
4) 4 hour history of back and leg pain
5) O/E Reduced air entry right base
6) Given morphine sc injection
Investigations

Management

Clinical Progress

Clinical Recovery
1) Slow improvement with antibiotics
2) Steady wean off O2 to maintain sats
3) Resolution of chest signs
4) Reduced analgesia requirements
5) Haemoglobin level stable Hb 90g/L
6) Discharge two weeks post admission
7) Follow-up in sickle disease clinic
Future Management

Life-threatening Complications - CHEST SYNDROME
1) Progressive hypoxia +/- fever
2) Pleuritic chest pain, patchy shadowing on CXR
Life-threatening Complications - BRAIN SYNDROME
1) Presents as stroke
2) Indication for exchange transfusion programme
Life-threatening Complications - APLASTIC CRISIS

Life-threatening Complications - ACUTE SEPSIS
1) Caused by hyposplenism
2) Major cause of death in Africa
What is DACTYLITIS?
Fingertips lost due to infarction

Example of CHEST CRISIS in infant

Example of AVASCULAR NECROSIS of femoral head

How does a BLOOD FILM of sickle cell anaemia look?
How is sickle cell anaemia DIAGNOSED?
Sickle solubility screening test
Positive for both sickle carrier and disease
Example of HAEMOGLOBIN ELECTROPHORESIS

Hb HPLC of sickle cell anaemia

Prevention Management - ANTENATAL SCREENING
1) Carried out in high prevalence areas
2) Can provide suitable genetic counselling at birth
Prevention Management - PROPHYLAXIS AGAINST INFECTIONS
1) Penicillin prophylaxis
2) Vaccination:
Pneumovax / meningovax / haemophilus (HIB)
Prevention Management - PREVENTION OF CRISES
1) Avoid infections, hypoxia, dehydration
2) Hydroxycarbamide, exchange transfusions
How do you MANAGE CRISES?
1) Exclude underlying infection
2) Oxygen
3) Analgesia
NSAID’s
Opiates (morphine – sub-cut injections weaned to oral)
Avoid pethidine (seizures and addiction)
4) Intravenous fluids
5) Antibiotics
6) Monitor FBC and reticulocyte count
What are the PREVENTITIVE MEASURES of STROKE for sickle cell anemia?
1) Transcranial Doppler scan predictive of stroke
2) If blood flow >200cm/sec the risk of stroke is significantly increased
3) Risk reduced by exchange transfusions
4) Aim to reduce HbS level to below 30%
5) Hydroxycarbamide therapy if unable to transfuse
What is EXCHANGE TRANSFUSION?
1) Manually or with cell separator machine
2) Aim to reduce HbS level to <30%
3) Extended blood cross-matching to get good blood match
What are the INDICATIONS of exchange transfusion?
1) Chest syndrome
2) Stroke
3) Major surgery
4) Recurrent severe crises
5) Priapism
What are the COMPLICATIONS of sickle cell disease?

What is HYDROXYCARBAMIDE therapy?
Trial of hydroxycarbamide showed it reduced the frequency of crises, chest syndromes and transfusions in SCD
How does hydroxycarbamide therapy work?
Hydroxycarbamide (also known as hydroxyurea):
1) Ribonucleotide reductase inhibitor
2) Induces stress haematopoiesis
3) Increases in HbF (fetal Hb) production
4) Reduces WCC and platelets
5) Reduces expression of adhesion molecules
6) Increases nitric oxide production
What is GLOBIN GENE LOCI?

What is Hb GENE SWITCHING?
Hydroxycarbamide induces reactivation of gamma globin locus resulting in increased fetal Hb (HbF)

What is HEREDITARY PERSISTANCE OF FH?
1) Some patients have hereditary persistence of fetal Hb (HPFH) with HbF levels over 20%
2) These patients have fewer crises and a milder clinical phenotype
3) Understanding the biology of Hb genes might yield new therapies that increase HbF production

What is ALLOGENIC STEM CELL TRANSPLANT?
1) Transplantation - potentially curative in sickle cell disease
2) Survival 90-95%, 80-85% cured
3) Patients usually below 16 years
4) SCT may be indicated in patients with history of strokes, recurrent chest syndromes or severe painful crises
5) Post-transplant infertility is likely
6) 5-10% risk of chronic GvHD
How is GENE THERAPY used for SCD?

What is VOXELOTOR?
Disrupts polymerization of HbS Hb